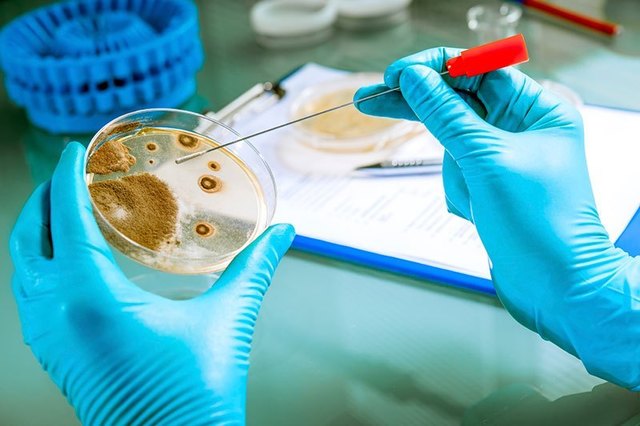
Por primera vez se consigue trasplantar un genoma

-
Publica sus experimentos con plantas híbridas, y llama a los resultados de su investigación “Leyes de la herencia”.
-
Aisló los núcleos de células presentes en pus de vendajes quirúrgicos, y comprobó que los núcleos contenían una sustancia química homogénea y no proteica a la que denominó Nucleína
-
Demostró que la nucleína contenía proteínas y moléculas básicas ricas en nitrógeno, lo que llevó a la identificación de las bases nitrogenadas.
-
Denomina Ácidos Nucleicos a la Nucleína
-
Esta teoría plantea que los alelos mendelianos están localizados en los cromosomas.
-
Puso de manifiesto que los ácidos nucleicos estaban compuestos de ácido fosfórico, una pentosa y las bases nitrogenadas.
-
Observó una mosca mutante de ojos blancos entre individuos de estirpe silvestre de ojos rojos. Luego de descubrir que era macho decidió usarlo como semental para observar cómo iría pasando de generación en generación la nueva característica de ojos blancos.
-
Demostró que los genes están en los
cromosomas. -
Una de las cosas que se establecen es que los factores elementales de los que Mendel hablaba (genes) formaban parte de los cromosomas y que, por lo tanto, los genes podían ser tratados como puntos específicos a lo largo de los cromosomas, permitiendo su localización dentro de ellos.
-
Este experimento le permitió descubrir a Frederick Griffith lo que el denominó como 'principio transformador' a lo que actualmente se conoce como ADN.
-
y propusieron que el ADN era una fibra compuesta de bases nitrogenadas apiladas a 0.33 nm unas de otras, perpendiculares al eje de la molécula.
-
-
Expusieron una Neurospora crassa a rayos X , los cuales causaron mutaciones que originaban cambios en las enzimas implicadas en rutas metabólicas. Como resultado, proponían un vínculo directo entre los genes y las enzimas, conocido como la hipótesis “Un gen, una enzima”.
-
Demostraron que las mutaciones en E. coli ocurrían de forma espontánea, sin necesidad de exposición a agentes mutagénicos, y que éstas se transmitían siguiendo las leyes de la herencia.
-
Demostraron que las cepas inocuas de neumococo estudiadas por Griffith se transformaban en patógenas al adquirir la moléculas de ADN y no proteínas, demostrando con esto que el Principio transformador era el ADN.
-
Demostró que el ADN aislado de diferentes organismos contiene la misma proporción de Adeninas y de Timinas, así como de citosinas y de guaninas. Asimismo, demostró que el porcentaje de bases purinas era igual al de bases pirimidinas
-
Realizaron un experimento utilizando bacteriófagos marcados con
isótopos radiactivos 35S o 32P, para demostrar que cuando un virus infecta a una bacteria solamente penetra el ADN viral. La cápside no se introduce a la bacteria y, por lo tanto, no participa en la
formación de nuevas partículas virales, y concluyeron que
el ADN, y no las proteínas, contiene la información genética
para la síntesis de nuevos viriones. -
Mediante estudios de difracción de rayos X, la quimicofísica descubrió que el ADN presentaba los grupos fosfato hacia el exterior y podía hallarse de dos formas helicoidales distintas
-
Elaboraron el famoso modelo de la doble hélice de ADN, que explicaba de manera clara que el ADN podía duplicarse y transmitirse de una célula a otra. Su maqueta representaba al ADN formado por dos cadenas antiparalelas: una que corre en dirección 5´-3´, y la otra que lo hace en la dirección opuesta 3´-5´, Este descubrimiento marcó el inicio de la Biología Molecular Moderna.
-
Siguiendo el modelo de la doble hélice, propuso la existencia de la
tautomería y la replicación semiconservadora del ADN, y
propuso que para la síntesis de proteínas debe existir una
molécula mediadora entre las proteínas y el ADN, función
que hoy se sabe realiza el ARN. -
-
Confirmaron la replicación semiconservadora propuesta por Crick. En su experimento utilizaron centrifugación con gradientes de soluciones de cloruro de cesio. Cultivaron bacterias en un medio que contenía el isotopo 15N (pesado) para marcar las cadenas de ADN progenitoras. Después cambiaron el medio por uno que contenía 14N (ligero) y se permitió que las células se replicaran tres veces, hasta que se comprobó que la replicación es semiconservativa.
-
-
-
Demostraron que el genoma de ARN de los retrovirus era copiado a una molécula de ADN de doble cadena por la acción de la transcriptasa inversa, durante la infección de estos virus.
-
-
-
Desarrolló la PCR, que permite la amplificación de una secuencia específica de ADN mediante nucleótidos trifosfatados y un ADN polimerasa.
-
-
Se inaugura el proyecto, cuyo objetivo fundamental de este proyecto: determinar la secuencia de pares de bases que componen el ADN e identificar los aproximadamente 30 000 genes del genoma humano.
-
Fue el primer mamífero clonado a partir de una célula adulta. Sus creadores fueron Ian Wilmut y Keith Campbell.
-
-
-
Microbiólogos liderados del J. Craig Venter Institute en Rockville ) consiguieron transferir un genoma entero compuesto por unos 500 genes de un microbio a otro, con lo que han logrado convertir a la segunda especie en la primera.
-
Los científicos tomaron las células de pacientes con diversas enfermedades y las reprogramaron como células madre. Las células transformadas crecieron en laboratorio, algo que no es posible con la mayoría de las células adultas.
-
-
Permite secuenciar de forma fiable el ADN, aunque no siempre es posible su reparación. Y es que, de las más de 60.000 anomalías genéticas que provocan enfermedades, un total de 35.000 están ocasionadas por un minúsculo error en estas bases. Esto permite mejorar la potencia de las herramientas de edición genética y permiten editar las letras del material genético con el objetivo de tratar de curar enfermedades y prevenirlas
-
Los anticuerpos de los camellos son 10 veces mas pequeños que los anticuerpos humanos, por eso pueden pueden unirse a sitios inaccesibles para los anticuerpos convencionales.
A list shows items. A timeline shows sequence.
Use Timetoast to make dates, milestones, and turning points easier to understand in a clear visual format. Timetoast is a timeline maker for work, school, research, and stories.